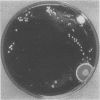
86

Abstract
Nocardia transvalensis can be a rare cause of actinomycotic mycetoma. A 40 year old man presented with his right arm showing multiple discharging sinuses, which had been present for four years. N transvalensis was isolated from a biopsy specimen. No other underlying disease was detected. The patient was successfully managed with surgical excision of the lesion and treatment with co-trimoxazole. This is the first case of N transvalensis infection to be reported from the Indian subcontinent as far as is known.
Full text
PDF

Images in this article
Selected References
These references are in PubMed. This may not be the complete list of references from this article.
- Goodfellow M., Fleming A., Sackin M. Differentiation of Mycobacterium rhodochrous and Runyon's group IV Mycobacteria using numerical taxonomic techniques. J Gen Microbiol. 1971 Dec;69(3):8–9. [PubMed] [Google Scholar]
- Gugnani H. C., Ojukwu J. O., Suseelan A. V. Mycetoma of thumb caused by Nocardia transvalensis. Mycopathologia. 1982 Oct 22;80(1):55–60. doi: 10.1007/BF00437179. [DOI] [PubMed] [Google Scholar]
- McNeil M. M., Brown J. M., Georghiou P. R., Allworth A. M., Blacklock Z. M. Infections due to Nocardia transvalensis: clinical spectrum and antimicrobial therapy. Clin Infect Dis. 1992 Sep;15(3):453–463. doi: 10.1093/clind/15.3.453. [DOI] [PubMed] [Google Scholar]
- McNeil M. M., Brown J. M., Jarvis W. R., Ajello L. Comparison of species distribution and antimicrobial susceptibility of aerobic actinomycetes from clinical specimens. Rev Infect Dis. 1990 Sep-Oct;12(5):778–783. doi: 10.1093/clinids/12.5.778. [DOI] [PubMed] [Google Scholar]
- Wallace R. J., Jr, Septimus E. J., Williams T. W., Jr, Conklin R. H., Satterwhite T. K., Bushby M. B., Hollowell D. C. Use of trimethoprim-sulfamethoxazole for treatment of infections due to Nocardia. Rev Infect Dis. 1982 Mar-Apr;4(2):315–325. doi: 10.1093/clinids/4.2.315. [DOI] [PubMed] [Google Scholar]